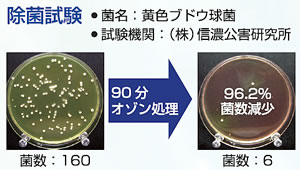

新入荷
再入荷
ピオニーコーポレーション 器具殺菌庫 衣服用乾燥式オゾン殺菌庫
 タイムセール
タイムセール
終了まで
00
00
00
999円以上お買上げで送料無料(※)
999円以上お買上げで代引き手数料無料
999円以上お買上げで代引き手数料無料
通販と店舗では販売価格や税表示が異なる場合がございます。また店頭ではすでに品切れの場合もございます。予めご了承ください。
商品詳細情報
| 管理番号 |
新品 :83163295107
中古 :83163295107-1 |
メーカー | 31eb1d49b5c8 | 発売日 | 2025-07-03 07:25 | 定価 | 947760円 | ||
|---|---|---|---|---|---|---|---|---|---|
| カテゴリ | |||||||||

![Not yet 西瓜BABY コネクティングカード 封入 Type-C [CD]](https://static.mercdn.net/item/detail/orig/photos/m38183824398_1.jpg)


![K3FH1-211028 レア[生存のための科学 ライフ・サイエンス 浦田卓]弁証法のウソ 記憶の座](https://auctions.c.yimg.jp/images.auctions.yahoo.co.jp/image/dr000/auc0210/users/b0d88ed13483b737a77a078d1e03a2325c01ca78/i-img1200x1200-1635396957qkj4hk423446.jpg)
![▲全国送料無料▲ はたらく魔王さま 柊暁生 [1-18巻 コミックセット/未完結]](https://auctions.c.yimg.jp/images.auctions.yahoo.co.jp/image/dr000/auc0208/users/89131d84d7fdc1fc63faa982da45592a28252e44/i-img670x510-1628354397vytla2551278.jpg)






